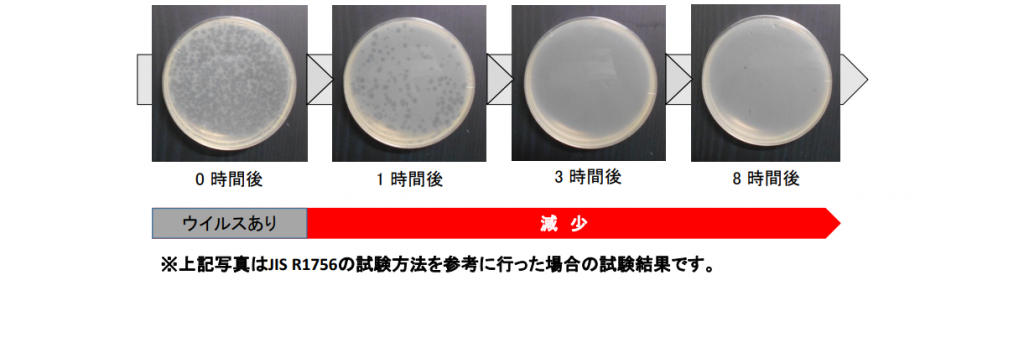

抗ウイルス
加工製品
病院・福祉施設など、不特定多数の人々が集まる場所へ、
より衛生的な
環境づくりに向けた製品。
抗ウイルス性能付
ポリ化粧板を使用した
SIAA登録製品
「抗ウイルス性能」を持つポリ化粧板を使用した家具の制作が可能です。

抗ウイルス加工ポリエステル化粧板

※抗ウイルス加工は、病気の治療や予防を目的とするものではありません。
抗ウイルス加工
ポリエステル化粧板の構成

効果と安全性の立証

目で見てわかる
抗ファージウイルス試験
抗ウイルス効果の持続性








































